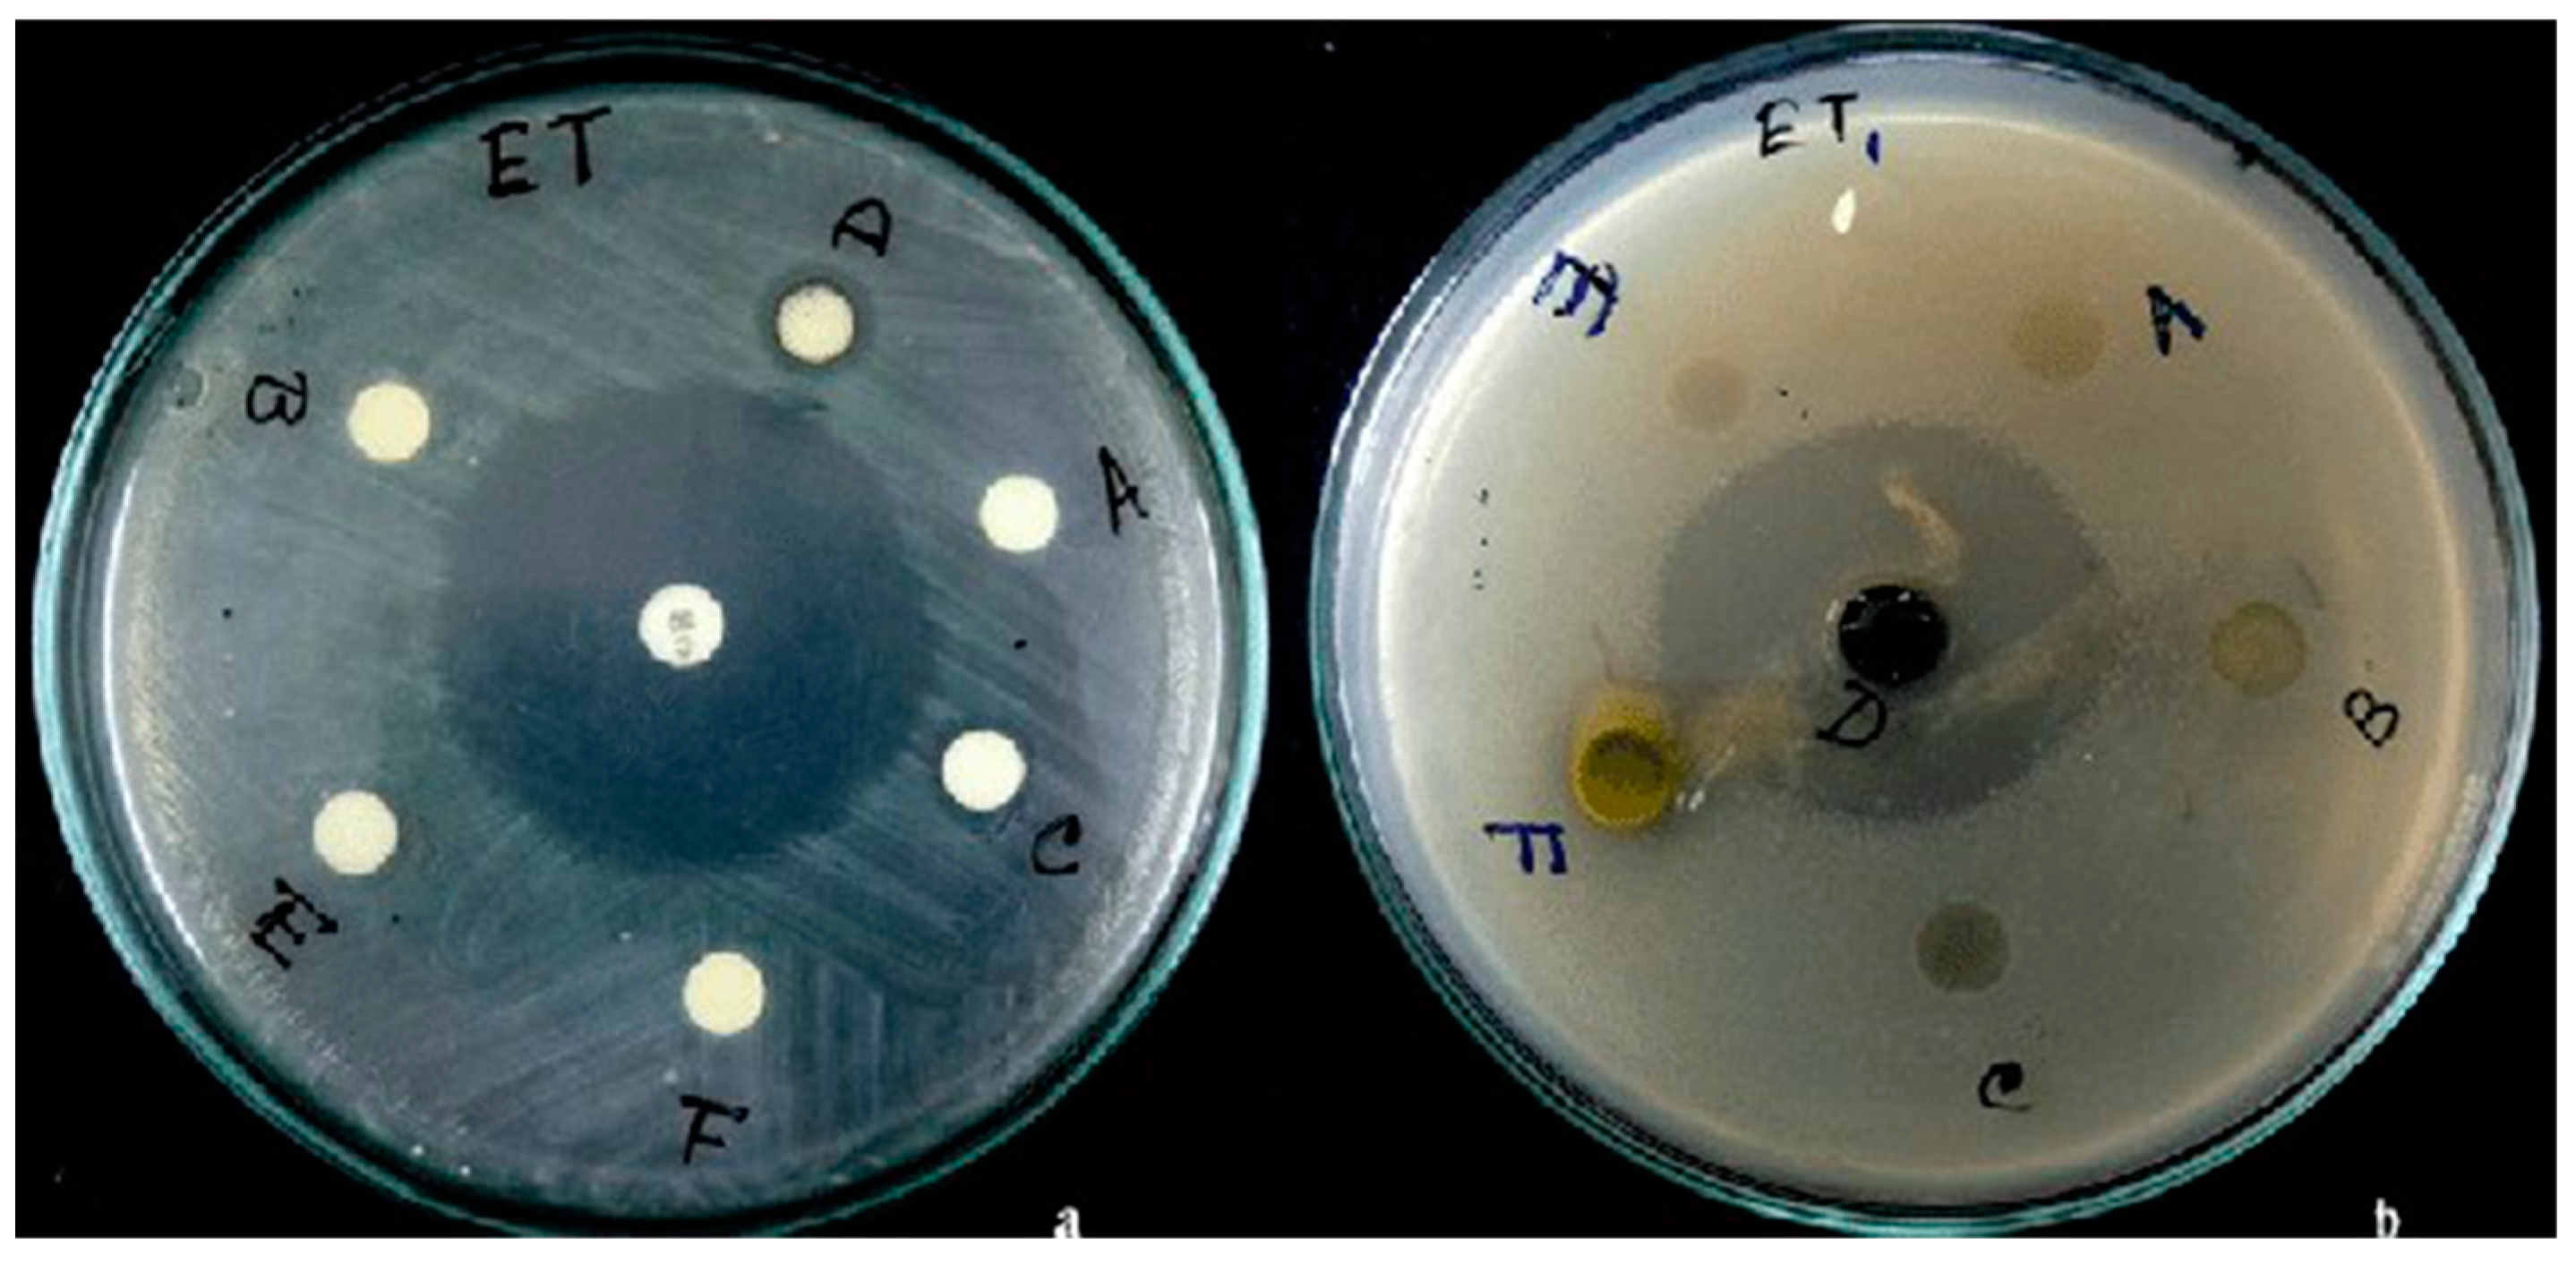
Antibiotics 10 00457 g008 Antibiotics 10 00457 g008

Comparative Studies on Different Extraction Methods of Centella asiatica and Extracts Bioactive Compounds Effects on Antimicrobial Activities
Abstract
1. Introduction
2. Techniques for Extracting Bioactive Compounds from Centella asiatica
2.1. Maceration
2.2. Distillation
2.3. Soxhlet Extraction
2.4. Ultrasound-Assisted Extraction
2.5. Microwave Extraction
2.6. Subcritical Water Extraction
3. Antimicrobial Activity
3.1. In Vitro Studies
3.2. In Vivo Studies
4. Safety and Toxicology
5. Conclusions
Author Contributions
Funding
Institutional Review Board Statement
Informed Consent Statement
Data Availability Statement
Acknowledgments
Conflicts of Interest
References
- Ekor, M. The growing use of herbal medicines: Issues relating to adverse reactions and challenges in monitoring safety. Front. Neurol. 2014, 4, 1–10. [Google Scholar] [CrossRef]
- Hussin, F.; Eshkoor, S.A.; Rahmat, A.; Othman, F.; Akim, A. The Centella asiatica juice effects on DNA damage, apoptosis and gene expression in hepatocellular carcinoma (HCC). BMC Complement. Altern. Med. 2014, 32, 1–7. [Google Scholar] [CrossRef]
- Sabaragamuwa, R.; Perera, C.O.; Fedrizzi, B. Centella asiatica (Gotu kola) as a neuroprotectant and its potential role in healthy ageing. Trends Food Sci. Technol. 2018, 79, 88–97. [Google Scholar] [CrossRef]
- Mohd Heikal, M.Y.; Siti Mariam, H.; Mohd Ilham, A.; Mee Fong, C.; Aminuddin, B.S.; Ruszymah, B.H.I. Anti-proliferative activities of Centella asiatica extracts on human respiratory epithelial cells in vitro. J. Med. Plant Res. 2014, 8, 864–869. [Google Scholar] [CrossRef][Green Version]
- Alfarra, H.Y.; Omar, M.N. Centella asiatica: From folk remedy to the medicinal biotechnology—A state revision. Int. J. Biosci. 2013, 3, 49–67. [Google Scholar]
- Monton, C.; Settharaksa, S.; Luprasong, C.; Songsak, T. An optimization approach of dynamic maceration of Centella asiatica to obtain the highest content of four centelloids by response surface methodology. Braz. J. Pharmacogn. 2019, 29, 254–261. [Google Scholar] [CrossRef]
- Saha, S.; Guria, T.; Singha, T.; Maity, T.K. Evaluation of analgesic and anti-inflammatory activity of chloroform and methanol extracts of Centella asiatica Linn. ISRN Pharmacol. 2013, 2013, 1–6. [Google Scholar] [CrossRef] [PubMed]
- Nurlaily, A.; Noor Baitee, A.; Musalmah, M. Comparative antioxidant and anti-inflammatory activity of different extracts of Centella asiatica (L.) urban and its active compounds, asiaticoside and madecassoside. Med. Health 2012, 7, 62–72. [Google Scholar]
- Abdulla, M.A.; Al-Bayaty, F.H.; Younis, L.T.; Abu Hassan, M.I. Anti-ulcer activity of Centella asiatica leaf extract against ethanol-induced gastric mucosal injury in rats. J. Med. Plants Res. 2010, 4, 1253–1259. [Google Scholar]
- Byakodi, M.K.; Bagewadi, Z.K.; Muddapur, U.M. Phytoconstituents profiling and evaluation of antimicrobial and antioxidant attributes of methanolic extract of Centella asiatica. Res. J. Pharm. Biol. Chem. Sci. 2018, 9, 493–500. [Google Scholar]
- Sarumathi, A.; Anbu, S.; Saravanan, N. Antibacterial activity of Centella asiatica (Linn.,) leaves. Int. J. Chem. Pharm. Sci. 2013, 1, 393–395. [Google Scholar]
- Harun, N.H.; Septama, A.W.; Wan Ahmad, W.A.N.; Suppian, R. The potential of Centella asiatica (Linn.) urban as an anti-microbial and immunomodulator agent: A review. Nat. Prod. Sci. 2019, 25, 92–102. [Google Scholar] [CrossRef]
- Soumyanath, A.; Zhong, Y.P.; Henson, E.; Wadsworth, T.; Bishop, J.; Gold, B.G.; Quinn, J.F. Centella asiatica extract improves behavioral deficits in a mouse model of Alzheimer’s disease: Investigation of a possible mechanism of action. Int. J. Alzheimer’s Dis. 2012, 381974. [Google Scholar] [CrossRef]
- Seevaratnam, V.; Banumathi, P.; Premalatha, M.R.; Sundaram, S.P.; Arumugam, T. Functional properties of Centella asiatica (L.): A review. Int. J. Pharm. Pharm. Sci. 2012, 4, 8–14. [Google Scholar]
- Long, H.S.; Stander, M.A.; Van Wyk, B.E. Notes on the occurrence and significance of triterpenoids (asiaticoside and related compounds) and caffeoylquinic acids in Centella species. S. Afr. J. Bot. 2012, 82, 53–59. [Google Scholar] [CrossRef]
- Gunathilake, K.D.P.P.; Ranaweera, K.K.D.S.; Rupasinghe, H.P.V. Response surface optimization for recovery of polyphenols and carotenoids from leaves of Centella asiatica using an ethanol-based solvent system. Food Sci. Nutr. 2019, 7, 528–536. [Google Scholar] [CrossRef] [PubMed]
- Vadlapudi, V.; Behara, M.; Kaladhar, D.S.V.G.K.; Suresh Kumar, S.V.N.; Seshagiri, B.; John Paul, M. Antimicrobial profile of crude extracts Calotropis procera and Centella asiatica against some important pathogens. Indian J. Sci. Technol. 2012, 5, 3132–3136. [Google Scholar] [CrossRef]
- Azwanida, N.N. A review on the extraction methods use in medicinal plants, principle, strength and limitation. Med. Aromat. Plants 2015, 4, 1–6. [Google Scholar] [CrossRef]
- Rengganaten, V. In Vitro Screening of Cytotoxic Effect and Antioxidant Activity of Pereskia bleo and Centella asiatica Crude Extracts. Bachelor’s Thesis, Universiti Tunku Abdul Rahman, Perak, Malaysia, 2013. [Google Scholar]
- Bylka, W.; Znajdek-awiżeń, P.; Studzińska-sroka, E.; Brzezińska, M. Centella asiatica in cosmetology. Postępy Dermatol. Alergol. 2013, 63, 46–49. [Google Scholar] [CrossRef] [PubMed]
- Azis, H.A.; Taher, M.; Ahmed, A.S.; Sulaiman, W.M.A.W.A.W.; Susanti, D.; Chowdhury, S.R.; Zakaria, Z.A. In vitro and in vivo wound healing studies of methanolic fraction of Centella asiatica extract. S. Afr. J. Bot. 2017, 108, 163–174. [Google Scholar] [CrossRef]
- Lu, L.; Ying, K.; Wei, S.; Fang, Y.; Liu, Y.; Lin, H.; Ma, L.; Mao, Y. Asiaticoside induction for cell-cycle progression, proliferation and collagen synthesis in human dermal fibroblasts. Basic Sci. Rev. 2004, 43, 801–807. [Google Scholar] [CrossRef] [PubMed]
- Transparency Market Research. Centella Asiatica Market—Global Industry Analysis, Size, Share, Trends, Growth, and Forecasts, 2020 to 2030. Available online: https://www.transparencymarketresearch.com/centella-asiatica-market.html (accessed on 25 February 2021).
- Sene, G.; Loiseau, A.; Lepetit, J.-C. Use of Compounds from Centella asiatica. WO 2007054211, 18 October 2017. [Google Scholar]
- Loewy, Z.G.; Levine, W.Z.; Saffer, A.J. Oral Rinse. U.S. Patent 807,592,4B2, 13 December 2011. [Google Scholar]
- Montanez-Soto, F.L. Pharmaceutical Composition Based on Centella asiatica (Hydrocotyle asiatica L.) for the Treatment of Lower Limb Ulcers. U.S. Patent 10,232,004, 17 March 2016. [Google Scholar]
- Palpu, P.; Rao, C.V.; Kishore, K.; Gupta, Y.K.; Kartik, R.; Govindrajan, R. Herbal Formulation as Memory Enhancer in Alzheimer Condition. U.S. Patent 7,429,397, 29 June 2006. [Google Scholar]
- Kodgule, M.M.; Kumar, Y. Topical Hair Composition. WO 2020234794A1, 26 November 2020. [Google Scholar]
- Prasad, A.; Mathur, A.K.; Mathur, A. Advances and emerging research trends for modulation of centelloside biosynthesis in Centella asiatica (L.) Urban—A review. Ind. Crops Prod. 2019, 141, 111768. [Google Scholar] [CrossRef]
- Ved, D.K.; Goraya, G.S. Demand and Supply of Medicinal Plants in India; National Medicinal Plants Board, New Delhi & FRLHT: Bangalore, India, 2007. [Google Scholar]
- Vinolina, N.S. Centelloside content of cultivated pegagan (Centella asiatica) with application of phosporus fertilizer. J. Phys. Conf. Ser. 2018, 1116, 052072. [Google Scholar] [CrossRef]
- Paudel, P.; Satyal, P.; Dosoky, N.S.; Setzer, W.N. Chemical composition and biological activity of Centella asiatica essential oil from Nepal. Am. J. Essent. Oils Nat. Prod. 2017, 5, 5–8. [Google Scholar]
- Yahya, N.A.; Attan, N.; Wahab, R.A. An overview of cosmeceutically relevant plant extracts and strategies for extraction of plant-based bioactive compounds. Food Bioprod. Process. 2018, 112, 69–85. [Google Scholar] [CrossRef]
- Zhang, Q.W.; Lin, L.G.; Ye, W.C. Techniques for extraction and isolation of natural products: A comprehensive review. Chin. Med. 2018, 13, 1–26. [Google Scholar] [CrossRef] [PubMed]
- Duval, C. Method for Preparing Extract of Centella asiatica. U.S. Patent 948,755,2B2, 4 July 2013. [Google Scholar]
- Kim, K.; Lee, S.-Y.; Seo, S.-K.; Hwang, B.-R.; Park, J.-K. Water-Soluble Extract of Asiaticoside and Madecassoside from Centella asiatica and Isolating Method Thereof. U.S. Patent 641,734,9B1, 9 July 2002. [Google Scholar]
- Loiseau, A.; Sene, G.; Theron, E. Method for Preparing Centella asiatica Extract rich in Madecassoside and in Terminoloside. U.S. Patent 848,690,0B2, 16 July 2013. [Google Scholar]
- Desai, J.V.; Thomas, R.; Kamat, S.D.; Kamat, D.V. Microwave assisted extraction of saponins from Centella asiatica and its in vitro anti-inflammatory study. Asian J. Biochem. Pharm. Res. 2011, 1, 330–334. [Google Scholar]
- Hiranvarachat, B.; Devahastin, S.; Soponronnarit, S. Comparative evaluation of atmospheric and vacuum microwave-assisted extraction of bioactive compounds from fresh and dried Centella asiatica L. leaves. Int. J. Food Sci. Technol. 2015, 50, 750–757. [Google Scholar] [CrossRef]
- Kim, W.; Kim, J.; Veriansyah, B.; Kim, J.; Lee, Y.; Oh, S.; Tjandrawinata, R.R. Extraction of bioactive components from Centella asiatica using subcritical water. J. Supercrit. Fluids 2009, 48, 211–216. [Google Scholar] [CrossRef]
- Kumari, S.; Deori, M.; Elancheran, R.; Kotoky, J.; Devi, R. In vitro and in vivo antioxidant, anti-hyperlipidemic properties and chemical characterization of Centella asiatica (L.) extract. Front. Pharmacol. 2016, 7, 1–12. [Google Scholar] [CrossRef]
- Niamnuy, C.; Charoenchaitrakool, M.; Mayachiew, P.; Devahastin, S. Bioactive compounds and bioactivities of Centella asiatica (L.) urban prepared by different drying methods and conditions. Dry. Technol. Int. J. 2013, 31, 2007–2015. [Google Scholar] [CrossRef]
- Agme-ghodke, V.; Agme, R.N.; Sagar, A.D. Analysis of bioactive compounds in leaves extract of Centella asiatica by using HRLC-MS & IR techniques. J. Chem. Pharm. Res. 2016, 8, 122–125. [Google Scholar]
- Florczak, M.C. Extraction and Characterisation of the Essential Oil from Centella asiatica (Pennywort) Growing in South Africa. Master’s Thesis, University Witwatersrand, Johannesbg, South Africa, 2014. [Google Scholar]
- Joshi, D.R.; Adhikari, N. An overview on common organic solvents and their toxicity. J. Pharm. Res. Int. 2019, 28, 1–18. [Google Scholar] [CrossRef]
- Govarthanan, M.; Rajinikanth, R.; Kamala-kannan, S.; Selvankumar, T. A comparative study on bioactive constituents between wild and in vitro propagated Centella asiatica. J. Genet. Eng. Biotechnol. 2015, 13, 25–29. [Google Scholar] [CrossRef]
- Thamarai Selvi, P.; Senthil Kumar, M.; Rajesh, R.; Kathiravan, T. Antidepressant activity of ethanolic extract of leaves of Centella asiatica. Linn by in vivo methods. Asian J. Res. Pharm. Sci. 2012, 2, 76–79. [Google Scholar]
- Shen, Y.; Liu, A.; Ye, M.; Wang, L.; Chen, J.; Wang, X.; Han, C. Analysis of biologically active constituents in Centella asiatica by microwave-assisted extraction combined with LC–MS. Chromatographia 2009, 70, 431–438. [Google Scholar] [CrossRef]
- Rafamantanana, M.H.; Rozet, E.; Raoelison, G.E.; Cheuk, K.; Ratsimamanga, S.U.; Hubert, P.; Quetin-Leclercq, J. An improved HPLC-UV method for the simultaneous quantification of triterpenic glycosides and aglycones in leaves of Centella asiatica (L.) Urb (APIACEAE). J. Chromatogr. B Anal. Technol. Biomed. Life Sci. 2009, 877, 2396–2402. [Google Scholar] [CrossRef]
- Rahman, M.; Hossain, S.; Rahaman, A.; Fatima, N.; Nahar, T.; Uddin, B. Antioxidant activity of Centella asiatica (Linn.) urban: Impact of extraction solvent polarity. J. Pharmacogn. Phytochem. 2013, 1, 27–32. [Google Scholar]
- Borhan, M.Z.; Ahmad, R.; Rusop, M.; Abdullah, S. Green extraction: Enhanced extraction yield of asiatic acid from Centella asiatica (L.) nanopowders. J. Appl. Chem. 2013, 2013, 1–7. [Google Scholar] [CrossRef]
- Sellathoroe, S.; Marimuthu, S.; Ramays, T.R. Comparison of different extraction methods to study the antimicrobial activity of Centella asiatica leaf extracts. Int. J. Adv. Res. 2019, 7, 344–347. [Google Scholar] [CrossRef]
- Randriamampionona, D.; Diallo, B.; Rakotoniriana, F.; Rabemanantsoa, C.; Cheuk, K.; Corbisier, A.M.; Mahillon, J.; Ratsimamanga, S.; El Jaziri, M. Comparative analysis of active constituents in Centella asiatica samples from Madagascar: Application for ex situ conservation and clonal propagation. Fitoterapia 2007, 78, 482–489. [Google Scholar] [CrossRef] [PubMed]
- Sen, K.K.; Chouhan, K.B.S.; Tandey, R.; Mehta, R.; Mandal, V. Impact of microwaves on the extraction yield of phenolics, flavonoids, and triterpenoids from Centella leaves: An approach toward digiti botanical extraction. Pharmacogn. Mag. 2019, 15, S267–S273. [Google Scholar] [CrossRef]
- Idris, F.N.; Nadzir, M.M.; Abd Shukor, S.R. Optimization of solvent-free microwave extraction of Centella asiatica using Taguchi method. J. Environ. Chem. Eng. 2020, 8, 103766. [Google Scholar] [CrossRef]
- Wang, C.; Han, W.; Fan, L.; Wang, C. Enzymatic pretreatment and microwave extraction of asiaticoside from Centella asiatica. J. Biomed. Sci. Eng. 2009, 2, 526–531. [Google Scholar] [CrossRef]
- Albuquerque, B.R.; Prieto, M.A.; Barreiro, M.F.; Rodrigues, A.E.; Curran, T.P.; Barros, L.; Ferreira, I.C.F.R. Catechin-based extract optimization obtained from Arbutus unedo L. fruits using maceration/microwave/ultrasound extraction techniques. Ind. Crop. Prod. 2017, 95, 404–415. [Google Scholar] [CrossRef]
- Safdar, M.N.; Kausar, T.; Jabbar, S.; Mumtaz, A.; Ahad, K.; Saddozai, A.A. Extraction and quantification of polyphenols from kinnow (Citrus reticulate L.) peel using ultrasound and maceration techniques. J. Food Drug Anal. 2017, 25, 488–500. [Google Scholar] [CrossRef]
- Pittella, F.; Dutra, R.C.; Junior, D.D.; Lopes, M.T.P.; Barbosa, N.R. Antioxidant and cytotoxic activities of Centella asiatica (L). Int. J. Mol. Sci. 2009, 10, 3713–3721. [Google Scholar] [CrossRef]
- Cosmetic Ingredient Review. Safety Assessment of Centella asiatica-Derived Ingredients as Used in Cosmetics. 2015. Available online: https://www.cir-safety.org/sites/default/files/centel062015FR.pdf (accessed on 2 February 2021).
- Zhao, C.; He, X.; Li, C.; Yang, L.; Fu, Y.; Wang, K.; Zhang, Y.; Ni, Y. A microwave-assisted simultaneous distillation and extraction method for the separation of polysaccharides and essential oil from the leaves of Taxus chinensis Var. mairei. Appl. Sci. 2016, 6, 19. [Google Scholar] [CrossRef]
- Lucchesi, M.E.; Chemat, F.; Smadja, J. Solvent-free microwave extraction of essential oil from aromatic herbs: Comparison with conventional hydro-distillation. J. Chromatogr. A 2004, 1043, 323–327. [Google Scholar] [CrossRef]
- Orhan, I.E.; Atasu, E.; Senol, F.S.; Ozturk, N.; Demirci, B.; Das, K.; Sekeroglu, N. Comparative studies on Turkish and Indian Centella asiatica (L.) Urban (gotu kola) samples for their enzyme inhibitory and antioxidant effects and phytochemical characterization. Ind. Crops Prod. 2013, 47, 316–322. [Google Scholar] [CrossRef]
- Zhuoyan, H. Microwave Assisted Extraction: The Effects, Mechanisms and Applications on Selected Plant Materials. Ph.D. Thesis, The Hong Kong Polytechnic University, Hong Kong, China, 2011. [Google Scholar]
- Jayaprakash, S.B.; Nagarajan, N. Studies on the bioactive compounds and antimicrobial activities of medicinal plant Centella asiatica (Linn). J. Med. Plants Stud. 2016, 4, 181–185. [Google Scholar]
- Chew, K.K.; Khoo, M.Z.; Ng, S.Y.; Thoo, Y.Y.; Aida, W.M.W.; Ho, C.W. Effect of ethanol concentration, extraction time and extraction temperature on the recovery of phenolic compounds and antioxidant capacity of Centella asiatica extracts. Int. Food Res. J. 2011, 18, 1427–1435. [Google Scholar] [CrossRef]
- Bimakr, M.; Rahman, R.A.; Saleena Taip, F.; Adzahan, N.M.; Islam Sarker, Z.; Ganjloo, A. Ultrasound-assisted extraction of valuable compounds from winter melon (Benincasa hispida) seeds. Int. Food Res. J. 2013, 20, 331–338. [Google Scholar]
- Jemain, S.F.P.; Jamal, P.; Raus, A.R.; Amid, A.; Jaswir, I. Effects of process conditions on the ultrasonic extraction of phenolics scavenger from Curcuma caesia rhizome. Int. Food Res. J. 2017, 24, 422–427. [Google Scholar]
- Danlami, J.M.; Arsad, A.; Ahmad Zaini, M.A.; Sulaiman, H. A comparative study of various oil extraction techniques from plants. Rev. Chem. Eng. 2014, 30, 605–626. [Google Scholar] [CrossRef]
- Mutalib, L.Y. Comparison between conventional and modern methods for extraction of Rosmarinus officinalis leaves. Zanco J. Med. Sci. 2015, 19, 1029–1034. [Google Scholar] [CrossRef]
- Nithyanandam, R.; Shapheri, M.R.; Nasir, M.H. Antioxidant potential of Malaysian Herb Centella asiatica. Int. Conf. Environ. Chem. Biol. 2014, 78, 56–60. [Google Scholar] [CrossRef]
- Seo, S.B.; Kim, Y.M. Improving cosmetic activity by optimizing Centella asiatica extraction process. Nat. Prod. Commun. 2019, 14, 1–4. [Google Scholar] [CrossRef]
- Arumugam, T.; Ayyanar, M.; Justin, Y.; Pillai, K. Phytochemical screening and antibacterial activity of leaf and callus extracts of Centella asiatica. Bangladesh J. Pharmacol. 2011, 6, 55–60. [Google Scholar] [CrossRef]
- Chan, C.H.; Yusoff, R.; Ngoh, G.C.; Kung, F.W.L. Microwave-assisted extractions of active ingredients from plants. J. Chromatogr. A 2011, 1218, 6213–6225. [Google Scholar] [CrossRef] [PubMed]
- James, J.T.; Dubery, I.A. Pentacyclic triterpenoids from the medicinal herb, Centella asiatica (L.) Urban. Molecules 2009, 14, 3922–3941. [Google Scholar] [CrossRef] [PubMed]
- Soyingbe, O.S.; Mongalo, N.I.; Makhafola, T.J. In vitro antibacterial and cytotoxic activity of leaf extracts of Centella asiatica (L.) Ur, Warburgia salutaris (Bertol. F.) Chiov and Curtisia dentata (Burm. F.) C.A.Sm-medicinal plants used in South Africa. BMC Complement. Altern. Med. 2018, 3, 1–10. [Google Scholar]
- Dhiman, R.; Aggarwal, N.; Aneja, K.R.; Kaur, M. In vitro antimicrobial activity of spices and medicinal herbs against selected microbes associated with juices. Int. J. Microbiol. 2016, 1–9. [Google Scholar] [CrossRef]
- Kalemba, D.; Kunicka, A. Antibacterial and antifungal properties of essential oils. Curr. Med. Chem. 2005, 10, 813–829. [Google Scholar] [CrossRef]
- Arifullah, M.; Vikram, P.; Chiruvella, K.K.; Shaik, M.M.; Abdullah Ripain, I.H. A review on Malaysian plants used for screening of antimicrobial activity. Annu. Res. Rev. Biol. 2014, 4, 2088–2132. [Google Scholar] [CrossRef]
- Meena, A.K.; Khan, S.; Rao, M.M.; Reddy, R.K.; Padhi, M.M. Antifungal metabolites from plants used in Ayurvedic system of medicine in India. In Antifungal Metabolites from Plants; Razzaghi-Abyaneh, M., Rai, M., Eds.; Springer: Berlin/Heidelberg, Germany, 2013; pp. 303–331. ISBN 9783642380761. [Google Scholar]
- Sieberi, B.M.; Omwenga, G.I.; Wambua, R.K.; Samoei, J.C.; Ngugi, M.P. Screening of the dichloromethane: Methanolic extract of Centella asiatica for antibacterial activities against Salmonella typhi, Escherichia coli, Shigella sonnei, Bacillus subtilis, and Staphylococcus aureus. Sci. World J. 2020, 2020, 1–8. [Google Scholar] [CrossRef] [PubMed]
- Zheng, H.M.; Choi, M.J.; Kim, J.M.; Lee, K.W.; Park, Y.H.; Lee, D.H. In vitro and in vivo anti-Helicobacter pylori activities of Centella asiatica leaf extract. Prev. Nutr. Food Sci. 2016, 21, 197–201. [Google Scholar] [CrossRef]
- Jamal, P.; Karim, I.A.; Abdullah, E.; Raus, R.A.; Zuhanis, Y. Phytochemical screening for antibacterial activity of potential Malaysian medicinal plants. Afr. J. Biotechnol. 2011, 10, 18795–18799. [Google Scholar] [CrossRef]
- Gautam, R.; Saklani, A.; Jachak, S.M. Indian medicinal plants as a source of antimycobacterial agents. J. Ethnopharmacol. 2007, 110, 200–234. [Google Scholar] [CrossRef]
- Ferdous, N.; Rahman, M.; Alamgir, A.N.M. Investigation on phytochemical, cytotoxic and antimicrobial properties of ethanolic extracts of Centella asiatica (L.) Urban. J. Med. Plants Stud. 2017, 5, 187–188. [Google Scholar]
- Nasution, M.Y.; Restuati, M.; Pulungan, A.S.S.; Pratiwi, N. Antimicrobial activities of Centella asiatica leaf and root extracts on selected pathogenic micro-organisms. J. Med. Sci. 2018, 18, 198–2018. [Google Scholar] [CrossRef]
- Edgar, S.A. Analysis of Phenolics from Centella asiatica and Vernonia Amygdalina and Their Roles as Antibacterial and Antioxidant Compounds. Master’s Thesis, University Malaya, Kuala Lumpur, Malaysia, 2014. [Google Scholar]
- Purkait, S.; Jawahar Abraham, T.; Karmakar, S.; Dey, B.; Roy, A. Inhibition of fish pathogenic Aeromonas hydrophila and Edwardsiella tarda by Centella asiatica in-vitro. J. Aquac. Res. Dev. 2018, 9, 3–6. [Google Scholar] [CrossRef]
- Idris, F.N.; Nadzir, M.M. Antimicrobial activity of Centella asiatica on Aspergillus niger and Bacillus subtilis. Chem. Eng. Trans. 2017, 56, 1381–1386. [Google Scholar] [CrossRef]
- Suresh, M.; Alfonisan, M.; Alturaiki, W.; Al Aboody, M.S.; Alfaiz, F.A.; Premanathan, M.; Vijayakumar, R.; Umamagheswari, K.; Ghamdi, S.A.; Alsagaby, S.A. Investigations of bioactivity of Acalypha indica (L.), Centella asiatica (L.) and Croton bonplandianus (Baill) against multidrug resistant bacteria and cancer cells. J. Herb. Med. 2020, 100359. [Google Scholar] [CrossRef]
- Centers for Disease Control and Prevention. Antibiotic Resistance Threats in the United States, Atlanta, USA. Available online: https://www.cdc.gov/drugresistance/pdf/ar-threats-2013-508.pdf (accessed on 16 February 2021).
- Taemchuay, D.; Rukkwamsuk, T.; Sakpuram, T.; Ruangwises, N. Antibacterial activity of crude extracts of Centella asiatica against Staphylococcus aureus in bovine mastitis. Kasetsart Vet. 2009, 19, 119–128. [Google Scholar]
- Pitinidhipat, N.; Yasurin, P. Antibacterial activity of Chrysanthemum indicum, Centella asiatica and Andrographis paniculata against Bacillus cereus and Listeria monocytogenes under osmotic stress. Assumpt. Univ. J. Technol. 2012, 15, 239–245. [Google Scholar]
- Al-talib, H.; Mohamad Ali, N.D.; Suhaimi, M.H.; Rosli, S.S.N.; Othman, N.H.; Mansor, N.A.S.; Sulaiman Shah, A.K.; Ariffin, N.S.; Al-khateeb, A. Antimicrobial effect of Malaysian vegetables against enteric bacteria. Asian Pac. J. Trop. Biomed. 2016, 6, 211–215. [Google Scholar] [CrossRef]
- Kalita, D.; Saikia, J. Ethonomedicinal, antibacterial and antifungal potentiality of Centella asiatica, Nerium indicum and Cuscuta reflexa—Widely used in Tiwa tribe of Morigaon district of Assam, India. Int. J. Phytomed. 2012, 4, 380–385. [Google Scholar]
- Zaidan, M.R.S.; Noor Rain, A.; Badrul, A.R.; Adlin, A.; Norazah, A.; Zakiah, I. In vitro screening of five local medicinal plants for antibacterial activity using disc diffusion method. Trop. Biomed. 2005, 22, 165–170. [Google Scholar]
- Siti Nasiroh, I.; Zaleha, I.; Norazian, N. Antimicrobial effect of Centella asiatica extract on fish surimi. Politek. Kolej Komuniti J. Eng. Technol. 2016, 1, 101–107. [Google Scholar]
- Puttarak, P.; Panichayupakaranant, P. Short Communication: A new method for preparing pentacyclic triterpene rich Centella asiatica extracts. Nat. Prod. Res. 2013, 27, 684–686. [Google Scholar] [CrossRef]
- Bylka, W.; Znajdek-awi, P.; Studzińska-Sroka, E.; Dańczak-Pazdrowska, A.; Brzezińska, M. Centella asiatica in dermatology: An overview. Phyther. Res. 2014, 1–8. [Google Scholar] [CrossRef]
- Arora, R.; Kumar, R.; Agarwal, A.; Reeta, K.H.; Gupta, Y.K. Comparison of three different extracts of Centella asiatica for anti-amnesic, antioxidant and anticholinergic activities: In vitro and in vivo study. Biomed. Pharmacother. 2018, 105, 1344–1352. [Google Scholar] [CrossRef]
- Hastuti, N.S.; Taurhesia, S.; Wibowo, A.E. Aktivitas secara in vitro dan in vivo kombinasi ekstrak daun kelor (Moringa oleifera lam.) dan pegagan (Centella asiatica (L.). Urb.) sebagai gel anti jerawat. Intisari Sains Medis. 2019, 10, 629–636. [Google Scholar] [CrossRef]
- Rattanachaikunsopon, P.; Phumkhachorn, P. Use of Asiatic pennywort Centella asiatica aqueous extract as a bath treatment to control columnaris in Nile tilapia. J. Aquat. Anim. Health 2010, 22, 14–20. [Google Scholar] [CrossRef] [PubMed]
- Ramli, S.; Xian, W.J.; Azira, N.; Mutalib, A. A Review: Antibacterial activities, antioxidant properties and toxicity profile of Centella asiatica. Educ. JSMT 2020, 7, 39–47. [Google Scholar]
- Syahmi, A.R.M.; Vijayarathna, S.; Sasidharan, S.; Latha, Y.L.; Kwan, Y.P.; Lau, Y.L.; Shin, L.N.; Chen, Y. Acute oral toxicity and brine shrimp lethality of Elaeis guineensis jacq., (oil palm leaf) methanol extract. Molecules 2010, 15, 8111–8121. [Google Scholar] [CrossRef] [PubMed]
- Hamidi, M.R.; Jovanova, B.; Panovska, T.K. Toxicological evaluation of the plant products using brine shrimp (Artemia salina L.) model. Maced. Pharm. Bull. 2014, 60, 9–18. [Google Scholar] [CrossRef]
- Padmaja, R.; Arun, P.C.; Prashanth, D.; Deepak, M.; Amit, A.; Anjana, M. Brine shrimp lethality bioassay of selected Indian medicinal plants. Fitoterapia 2002, 73, 508–510. [Google Scholar] [CrossRef]
- Sultan, R.A.; Mahmood, S.B.Z.; Azhar, I.; Ahmed, S.W.; Mahmood, Z.A. Biological activities assessment of Centella asiatica (Linn.). J. Herbsspices Med. Plants 2014, 20, 319–327. [Google Scholar] [CrossRef]
- Selvi, C.K. Brine shrimp lethality assay of some medicinal plants using Artemia franciscana and Artemia salina. Int. J. Sci. Res. 2018, 7, 1901–1905. [Google Scholar] [CrossRef]
- Hashim, P. MiniReview: Centella asiatica in food and beverage applications and its potential antioxidant and neuroprotective effect. Int. Food Res. J. 2011, 18, 1215–1222. [Google Scholar]
- Gohil, K.J.; Patel, J.A.; Gajjar, A.K. Pharmacological review on Centella asiatica: A potential herbal cure-all. Indian J. Pharm. Sci. 2010, 72, 546–556. [Google Scholar] [CrossRef] [PubMed]
- European Medicines Agency. Assessment Report on Centella asiatica (L.) Urban, Herba. Available online: https://www.ema.europa.eu/en/documents/herbal-report/final-assessment-report-centella-asiatica-l-urban-herba-first-version_en.pdf (accessed on 22 February 2021).

| Extraction Method | Extraction Time | Sample Type | Solvent Type | Sample to Solvent Ratio (g/mL) | Additional Information | Compounds Extracted | References |
|---|---|---|---|---|---|---|---|
| Maceration | 6 h | Dried | 90% methanol | 10:100 | 66 °C | Phenolics, saponins | [38] |
| 24 h | Fresh | Ethanol | 5:25 | Room temperature | Saponins | [39] | |
| Dried | 0.5:25 | ||||||
| 5 h | Dried | Water, ethanol, methanol | 3:100 | Solvent boiling point | Asiaticoside, asiatic acid | [40] | |
| 120 min | Dried | 95% ethanol | 20:100 | 60 °C | Madecassoside, asiaticoside, asiatic acid, madecassic acid | [6] | |
| 30–90 min | Dried | Ethanol–water | 1:20 | 30–60 °C | Polyphenols, carotenoids | [16] | |
| 72 h | Dried | Distilled water | 100:1000 | - | Gluconic acid, ferulic acid, kaempferol, chlorogenic acid, asiatic acid | [41] | |
| 24 h | Fresh/dried | 80% ethanol–water | 1:20 | Room temperature | Phenolics, triterpene saponins | [42] | |
| - | Dried | Methanol, petroleum ether, chloroform | - | 60–80 °C | Triterpenoids, saponins, tannins, flavonoids | [7] | |
| 24 h | Powder | Methanol | 2:100 | Room temperature | Valine, triparanol, butamben, neuraminic acid, aesculin, esculetin, famciclovir, isocitretin, rhoifoline, gentiopicrin, urocortisone, pelargonic acid, gabapentin, ivermectin, sarmentoside, khivorin | [43] | |
| Distillation | 75 min | Dried | Xylene | 0.4:100 | - | Essential oil, α-caryophyllene, germacrene D | [44] |
| 3 h | Fresh | Water | - | - | Essential oil | [45] | |
| 4 h | Dried | Water | - | - | Essential oil | [32] | |
| Soxhlet | 12–24 h | Dried | Methanol | - | - | Phenolics, flavonoids, ascorbic acid | [46] |
| 8 h | Dried | Ethanol | 500:125 | - | Saponins, terpenoids, alkaloids, and phenols but no steroids, flavonoids, tannins, proteins, carbohydrates, or glycosides | [47] | |
| 1 h | Dried | Methanol–water (9:1) | 2:50 | - | Asiatic acid, asiaticoside, madecassoside | [48] | |
| 8 h | Dried | Methanol | 1:100 | - | Asiaticoside, madecassic acid, madecassoside, asiatic acid | [49] | |
| 6 h | Dried | Methanol | - | 60 °C | Alkaloids, phenols, tannins, flavonoids, terpenoids, and saponins | [10] | |
| - | Dried | Ethanol–water (1:1) | 1:10 | 45 ± 2 °C | Total polyphenols, flavonoids, β-carotene, tannins, and vitamin C | [50] | |
| Ultrasound-assisted extraction (UAE) | 1 h | Dried | Methanol–water (9:1) | 2:50 | - | Asiatic acid, asiaticoside, madecassoside | [48] |
| 20 min | Dried | Water | 0.6:50 | 125 W | Asiatic acid | [51] | |
| 5 h | Dried | Ethyl acetate–water (99:1) | 6:150 | Frequency: 40 kHz; temperature: 70 °C; power: 216 W | Alkaloids, flavonoids, saponins, terpenoids | [52] | |
| 3 × 10 min | Dried | Methanol–water (9:1) | 1:10 | - | Asiatic acid, asiaticoside, madecassoside, madecassic acid | [53] | |
| Microwave-assisted extraction (MAE) | 20 min | Dried | Methanol–water (9:1) | 1:25 | - | Asiatic acid, asiaticoside, madecassoside | [48] |
| 6 min | Dried | Ethanol | 1:25 | Microwave power: 50%; 40% | Phenolics, triterpenoids Flavonoids | [54] | |
| 5 min with 2 min pauses | Dried | Methanol–water (9:1) | 10:100 | Microwave power: 100% | Phenolics, saponins | [38] | |
| 20 min | Fresh | Ethanol | 10:50 | Atmospheric | Triterpene saponins, TPC | [39] | |
| Dried | 1:50 | ||||||
| Vacuum microwave-assisted extraction (VMAE) | 20 min | Fresh | Ethanol | 10:50 | 20, 40, 60 kPa | Triterpene saponins | [39] |
| Dried | 1:50 | ||||||
| Solvent-free microwave extraction (SFME) | 15 min | Fresh | - | - | Microwave power: 300 W | Asiaticoside | [55] |
| Enzymatic pretreatment microwave extraction (EPME) | 110 s | Dried | 3% cellulase solution | 3:108 | Enzymolysis 30 min, 45 °C | Asiaticoside | [56] |
| Subcritical water extraction | 5 h | Dried | Deionized water | - | 250 °C, 40 MPa | Asiatic acid, asiaticoside | [40] |
| Extraction Method | Solvent | Antimicrobial Method | Microbes | Effect | References |
|---|---|---|---|---|---|
| Maceration | Methanol, water | Open hole diffusion, 2-fold dilution method | Bacillus subtilis | + | [83] |
| Escherichia coli | − | ||||
| Aeromonas hydrophila | − | ||||
| Citrobacter freundii | − | ||||
| Maceration | Ethanol | Agar diffusion | Bacillus cereus | + | [93] |
| Listeria monocytogenes | + | ||||
| Maceration | Ethanol | Disc diffusion | Escherichia coli | + | [85] |
| Bacillus subtilis | + | ||||
| Vibrio cholerae | + | ||||
| Shigella sonnei | + | ||||
| Bacillus cereus | − | ||||
| Shigella dysenteriae | − | ||||
| Staphylococcus aureus | − | ||||
| Salmonella paratyphi | + | ||||
| Maceration | Ethanol | Disc diffusion | Staphylococcus aureus | + | [92] |
| Maceration | Water, methanol | Disc diffusion, agar well diffusion | Aeromonas hydrophila | − | [88] |
| Edwardsiella tarda | − | ||||
| Chloroform | Broth dilution, agar well diffusion, disc diffusion | Aeromonas hydrophila | + | ||
| Edwardsiella tarda | + | ||||
| Maceration | Water | Agar diffusion, Disc diffusion | Salmonella enterica | − | [94] |
| Shigella flexneri | − | ||||
| Escherichia coli | − | ||||
| Enterobacter cloacae | − | ||||
| Maceration | Ethanol | Agar well diffusion | Helicobacter pylori | + | [82] |
| Maceration | Methanol | Micro broth dilution | Mycobacterium sp. | + | [84] |
| Staphylococcus aureus | + | ||||
| Bacillus subtilis | + | ||||
| Aspergillus niger | + | ||||
| Candida albicans | + | ||||
| Escherichia coli | − | ||||
| Maceration | Acetone | Micro broth dilution | Bacillus cereus | + | [77] |
| Serratia sp. | − | ||||
| Rhodotorula mucilaginosa | − | ||||
| Aspergillus flavus | − | ||||
| Penicillium citrinum | − | ||||
| Methanol | Bacillus cereus | + | |||
| Serratia sp. | + | ||||
| Rhodotorula mucilaginosa | + | ||||
| Aspergillus flavus | + | ||||
| Penicillium citrinum | + | ||||
| Ethanol | Bacillus cereus | + | |||
| Serratia sp. | − | ||||
| Rhodotorula mucilaginosa | + | ||||
| Aspergillus flavus | + | ||||
| Penicillium citrinum | + | ||||
| Maceration | Dichloro-methane:methanol | Disc diffusion, micro broth dilution | Escherichia coli | + | [81] |
| Salmonella typhi | + | ||||
| Bacillus subtilis | + | ||||
| Staphylococcus aureus | + | ||||
| Shigella sonnei | + | ||||
| Maceration | Ethanol aqueous | Disc diffusion, agar dilution | Staphylococcus aureus | + | [42] |
| Maceration | Methanol, acetone, ethyl acetate | Agar diffusion, microplate dilution assay | Pseudomonas aeruginosa | + | [76] |
| Staphylococcus aureus | + | ||||
| Streptococcus agalactiae | + | ||||
| Bacillus cereus | + | ||||
| Enterococcus hirae | + | ||||
| Enterococcus faecalis (clinical isolate) | + | ||||
| Enterococcus gallinarum | + | ||||
| Escherichia coli | + | ||||
| Maceration | Aqueous | Disc diffusion | Streptococcus pyogenes | − | [86] |
| Pseudomonas aeruginosa | − | ||||
| Escherichia coli | + | ||||
| Staphylococcus aureus | + | ||||
| Staphylococcus albus | + | ||||
| Streptococcus pneumoniae | + | ||||
| Candida albicans | − | ||||
| Microsporum boulardii | − | ||||
| Aspergillus niger | + | ||||
| Aspergillus flavus | + | ||||
| Aqueous | Open hole diffusion | Streptococcus pneumoniae | − | ||
| Streptococcus pyogenes | − | ||||
| Pseudomonas aeruginosa | + | ||||
| Escherichia coli | + | ||||
| Staphylococcus aureus | + | ||||
| Staphylococcus albus | + | ||||
| Chloroform | Disc diffusion | Escherichia coli | + | ||
| Staphylococcus aureus | + | ||||
| Staphylococcus albus | + | ||||
| Pseudomonas aeruginosa | + | ||||
| Streptococcus pyogenesis | + | ||||
| Streptococcus pneumoniae | + | ||||
| Soxhlet | Ethanol, methanol | Disc diffusion | Aspergillus niger | + | [89] |
| Bacillus subtilis | + | ||||
| Soxhlet | Water | Disc diffusion | Escherichia coli | + | [11] |
| Klebsiella pneumoniae | + | ||||
| Staphylococcus aureus | + | ||||
| Streptococcus pyogenes | + | ||||
| Soxhlet | Aqueous | Agar well diffusion | Escherichia coli | + | [95] |
| Staphylococcus aureus | + | ||||
| Bacillus megaterium | + | ||||
| Vibrio parahaemolyticus | + | ||||
| Vibrio mimicus | + | ||||
| Shigella boydii | + | ||||
| Bacillus cereus | + | ||||
| Bacillus subtilis | + | ||||
| Shigella dysenteriae | + | ||||
| Salmonella typhi | + | ||||
| Salmonella Paratyphi | + | ||||
| Pseudomonas aeruginosa | + | ||||
| Escherichia coli | + | ||||
| Sarcina lutea | + | ||||
| Staphylococcus aureus | + | ||||
| Soxhlet | Methanol | Disc diffusion | Methicillin-resistant Staphylococcus aureus (MRSA) | + | [96] |
| Staphylococcus aureus | + | ||||
| Klebsiella pneumoniae | − | ||||
| Pseudomonas aeruginosa | − | ||||
| Escherichia coli | − | ||||
| Soxhlet | Methanol | Agar well diffusion | Micrococcus luteus | + | [10] |
| Staphylococcus aureus | + | ||||
| Bacillus subtilis | + | ||||
| Bacillus cereus | + | ||||
| Escherichia coli | + | ||||
| Pseudomonas aeruginosa | + | ||||
| Zymomonas mobilis | + | ||||
| Disc diffusion | Aspergillus niger | + | |||
| Aspergillus sydouri | + | ||||
| Trichoderma reesei | + | ||||
| Soxhlet | Methanol | Agar well diffusion | Aspergillus niger | + | [17] |
| Penicillium expansum | − | ||||
| Fusarium oxysporum | + | ||||
| Xanthomonas campestris | + | ||||
| Lactobacillus acidophilus | + | ||||
| Pseudomonas marginalis | + | ||||
| Pseudomonas syringae | + | ||||
| Pseudomonas aeruginosa | − | ||||
| Streptococcus mutans | − | ||||
| Streptococcus salivarius | + | ||||
| Staphylococcus aureus | + | ||||
| Soxhlet | Methanol | Disc diffusion | Proteus mirabilis | + | [65] |
| Streptococcus faecalis | + | ||||
| Streptococcus pyogenes | + | ||||
| Escherichia coli | + | ||||
| Fusarium oxysporum | + | ||||
| Alternaria alternata | + | ||||
| Curvularia lunata | + | ||||
| Petroleum ether | Staphylococcus aureus | − | |||
| Bacillus subtilis | − | ||||
| Bacillus thuringiensis | − | ||||
| Enterococcus faecalis | − | ||||
| Serratia marcescens | − | ||||
| Pseudomonas aeruginosa | − | ||||
| Proteus vulgaris | − | ||||
| Proteus mirabilis | − | ||||
| Klebsiella pneumoniae | − | ||||
| Escherichia coli | − | ||||
| Soxhlet | Ethanol | Disc diffusion | ESBL strains | [90] | |
| Escherichia coli | + | ||||
| Klebsiella pneumoniae | − | ||||
| Carbapenem-resistant strains | |||||
| Acinetobacter baumannii | − | ||||
| Klebsiella pneumoniae | + | ||||
| Pseudomonas aeruginosa | + | ||||
| Petroleum ether | ESBL strains | ||||
| Escherichia coli | − | ||||
| Klebsiella pneumoniae | + | ||||
| Carbapenem-resistant strains | |||||
| Acinetobacter baumannii | − | ||||
| Klebsiella pneumoniae | − | ||||
| Pseudomonas aeruginosa | − | ||||
| UAE | Methanol, acetone, chloroform, water | Agar well diffusion | Bacillus cereus | + | [73] |
| Escherichia coli | + | ||||
| Staphylococcus aureus | + | ||||
| Pseudomonas aeruginosa | + | ||||
| UAE | Methanol | Disc diffusion | Microbes in fish surimi | + | [97] |
| MAE | Ethanol | Disc diffusion | Streptococcus mutans | + | [98] |
| Streptococcus mitis | + | ||||
| Streptococcus pyogenes | + | ||||
Publisher’s Note: MDPI stays neutral with regard to jurisdictional claims in published maps and institutional affiliations. |
© 2021 by the authors. Licensee MDPI, Basel, Switzerland. This article is an open access article distributed under the terms and conditions of the Creative Commons Attribution (CC BY) license (https://creativecommons.org/licenses/by/4.0/).
Share and Cite
Idris, F.N.; Mohd Nadzir, M. Comparative Studies on Different Extraction Methods of Centella asiatica and Extracts Bioactive Compounds Effects on Antimicrobial Activities. Antibiotics 2021, 10, 457. https://doi.org/10.3390/antibiotics10040457
Idris FN, Mohd Nadzir M. Comparative Studies on Different Extraction Methods of Centella asiatica and Extracts Bioactive Compounds Effects on Antimicrobial Activities. Antibiotics. 2021; 10(4):457. https://doi.org/10.3390/antibiotics10040457
Chicago/Turabian StyleIdris, Farhana Nazira, and Masrina Mohd Nadzir. 2021. "Comparative Studies on Different Extraction Methods of Centella asiatica and Extracts Bioactive Compounds Effects on Antimicrobial Activities" Antibiotics 10, no. 4: 457. https://doi.org/10.3390/antibiotics10040457
APA StyleIdris, F. N., & Mohd Nadzir, M. (2021). Comparative Studies on Different Extraction Methods of Centella asiatica and Extracts Bioactive Compounds Effects on Antimicrobial Activities. Antibiotics, 10(4), 457. https://doi.org/10.3390/antibiotics10040457

